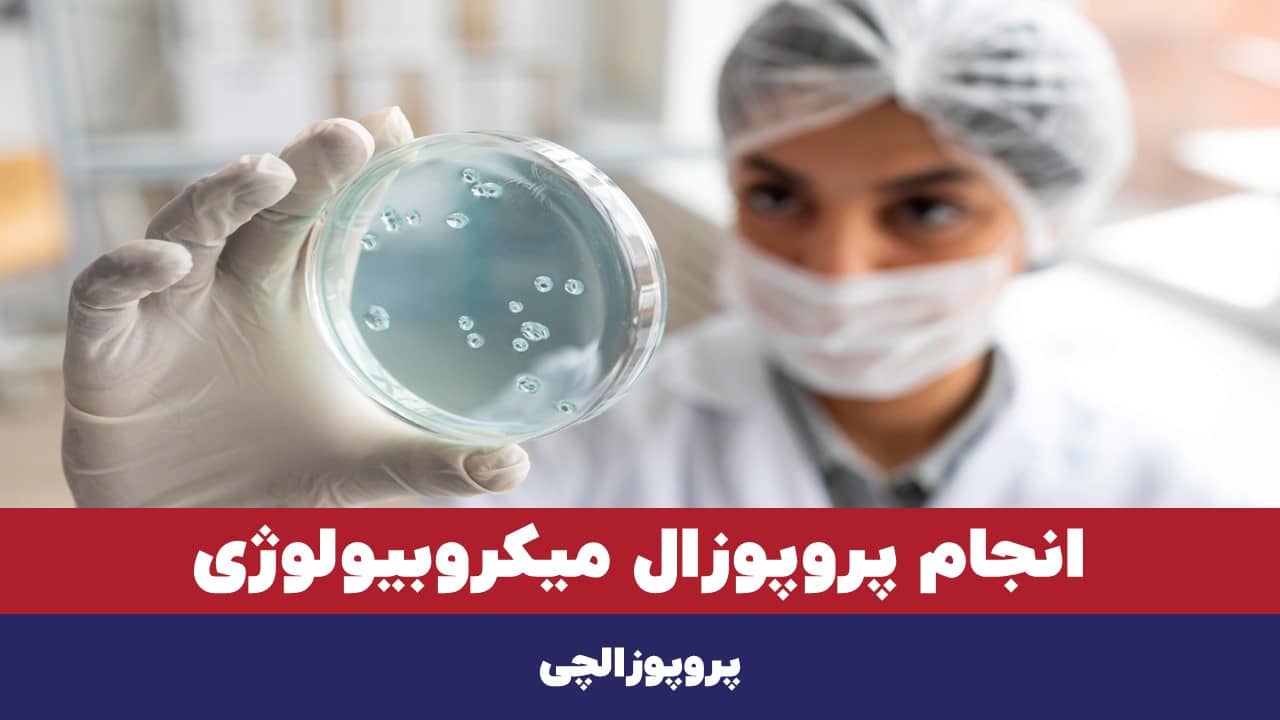
انجام پروپوزال میکروبیولوژی
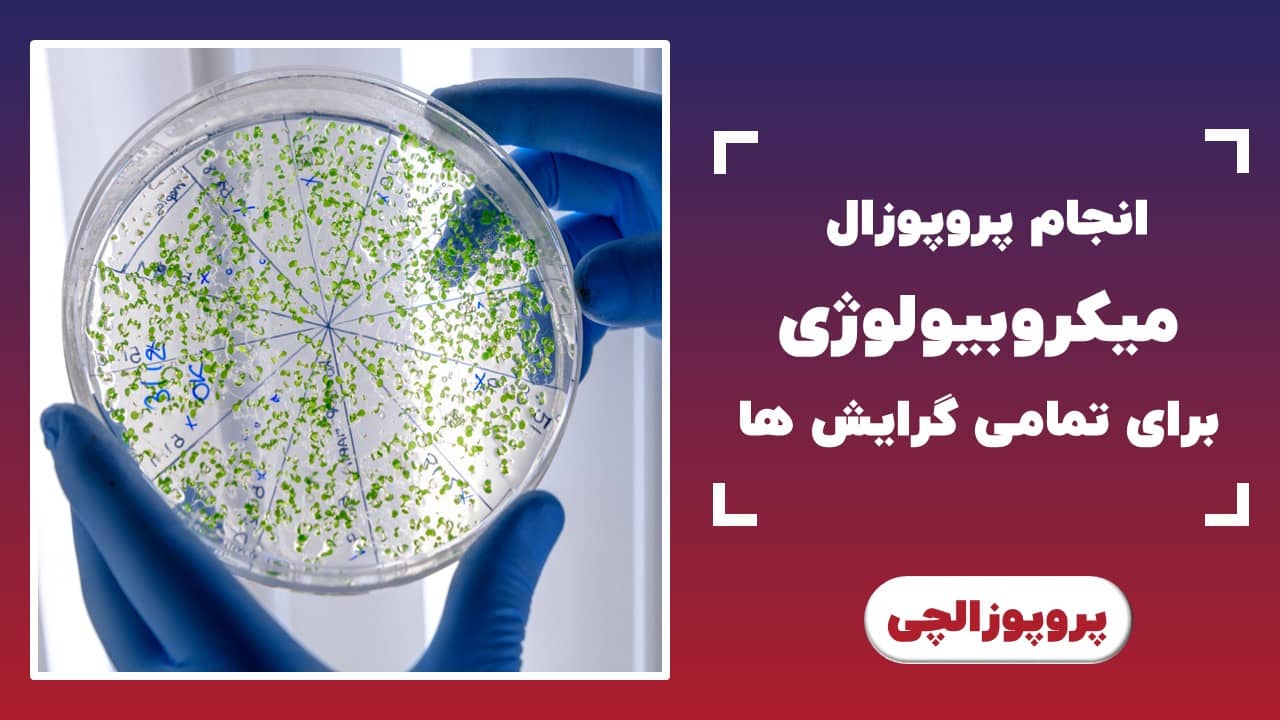
انجام پروپوزال میکروبیولوژی برای تمامی گرایش ها

در پروپوزالچی، مسیر نوشتن یک پروپوزال علمی دقیق و قابل دفاع را از همان قدم اول درست میچینیم؛ از انتخاب موضوع و طراحی روش تحقیق گرفته تا تنظیم متدولوژیهای حساس آزمایشگاهی مثل PCR و NGS. ما با تجربه نگارش صدها پروپوزال ارشد و دکتری رشته میکروبیولوژی، پروپوزالی مینویسیم که هم استاندارد دانشگاه را رعایت کند و هم نظر استاد را جلب کند. اگر میخواهید بدون سردرگمی و اتلاف وقت، پروپوزالی حرفهای تحویل دهید، همین حالا تماس بگیرید و سفارش انجام پروپوزال میکروبیولوژی خود را ثبت کنید.
انجام پروپوزال ارشد و دکتری رشته میکروبیولوژی با تضمین قیمت و کیفیت
فهرست مطالب
- انجام پروپوزال ارشد میکروبیولوژی برای تمامی گرایشها
- انجام پروپوزال دکتری میکروبیولوژی با رویکرد پژوهشی پیشرفته در پروپوزالچی
- مزایای انتخاب پروپوزالچی برای سفارش پروپوزال میکروبیولوژی
- قیمت پروپوزال میکروبیولوژی ارشد و دکتری در پروپوزالچی
- چرا پروپوزال میکروبیولوژی چالشبرانگیز است؟ ما راهحل داریم!
- سوالات متداول
- سخن پایانی: چرا پروپوزالچی بهترین انتخاب شماست؟
انجام پروپوزال ارشد میکروبیولوژی برای تمامی گرایشها
نوشتن پروپوزال میکروبیولوژی قبلاً اینقدر راحت نبود! دانشجو میبایست دانلود مقالات انگلیسی، خواندن و ترجمه آنها، استخراج خلأهای تحقیقاتی، ساختاربندی پروپوزال دقیق و … را خود انجام میداد. معمولاً هیچ متخصصی هم در دسترس نبود تا در نوشتن پروپوزال ارشد برای بار اول، او را راهنمایی کند.
اما با وجود وبسایتهایی مانند پروپوزالچی، بار بزرگی از دوش دانشجویان برداشته شد. ما همه مراحل انجام پروپوزال میکروبیولوژی ارشد را پیش میبریم و درباره نحوه پروپوزالنویسی یا محتوای علمی پروپوزال و موضوع آن، دانشجوی عزیز را بهطور تخصصی راهنمایی میکنیم. زمان آن رسیده که پروپوزالتان را به ما بسپارید و گامهایتان بهسوی موفقیت در انجام پایاننامه ارشد را با اعتماد به نفس بردارید.
برای آشنایی کامل با مراحل و خدمات ما در این مقطع، پیشنهاد میکنیم صفحه سفارش پروپوزال کارشناسی ارشد را مطالعه کنید.
میکروبهای بیماریزا
بهویژه در سالهای اخیر، تحقیقات این حوزه بهسرعت پیشرفت کردهاند. موضوعاتی مانند مقاومت به آنتیبیوتیکهای نسل جدید و شناسایی و درمان سویههای نوظهور با استفاده از تکنولوژیهای نوی، بیشتر مورد توجه بودهاند. این حوزهها نیاز به روششناسی دقیق و علمی دارند که ما در پروپوزالچی با استفاده از جدیدترین متدها به آن میپردازیم.
برای نوشتن پروپوزال میکروبهای بیماریزا، معتبرترین و پیشرفتهترین متدولوژیها را به کار میگیریم:
- توالییابی نسل جدید (NGS) برای شناسایی دقیق و سریع ژنوم پاتوژنها و بررسی جهشهای ژنتیکی
- کشتهای تکسویه برای جداسازی و شناسایی دقیق انواع میکروبها در محیطهای کنترلشده
- آنالیز بیوفیلمها و مطالعه اثرات درمانی بر میکروبهایی که در بیوفیلمها زندگی میکنند با استفاده از مدلهای in vitro
- روشهای ایمونولوژیک پیشرفته و طراحی آزمایشات ELISA و Western Blot برای شناسایی پروتئینها و آنتیبادیهای خاص میکروبها
میکروبیولوژی صنعتی
میکروبشناسی صنعتی، یکی از پرسرعتترین و نوآورانهترین حوزههای تحقیقاتی است. پایاننامههای ارشد در این گرایش، اخیراً بر فناوریهای زیستی نوین و فرآیندهای تولید پایدار تأکید داشتهاند. این حوزه نیاز به دقت بالا در انتخاب فرآیندها و مواد اولیه دارد که متخصصان ما تمام جزئیات آن را با دقت در نظر خواهند گرفت.
از متدولوژیهای زیر برای انجام پروپوزال میکروبیولوژی صنعتی استفاده میکنیم:
- بیوتکنولوژی، طراحی مدلهای تخمیر و شبیهسازی فرآیندهای صنعتی با استفاده از میکروارگانیسمها
- بررسی استفاده از میکروارگانیسمهای اصلاحشده برای تولید آنزیمهای خاص با بازده بالا
- مطرحسازی مهندسی ژنتیک میکروبی در تولید مواد بیولوژیکی و ویرایش ژنوم برای بهبود تولید و افزایش بازده
- آنالیز پایداری فرآیندهای صنعتی با استفاده از مدلهای ریاضی و شبیهسازی برای بررسی پایداری و بهینهسازی فرآیندها
میکروبشناسی محیطی
با توجه به اهمیت روزافزون میکروبشناسی محیطی در حل چالشهای زیستمحیطی، همواره به دانشجویان توصیه کردهایم که بر دو موضوع داغ اخیر تمرکز کنند؛ یعنی: استفاده از میکروبها در بیورمیدیشن برای پاکسازی آلایندهها و تأثیر تغییرات اقلیمی بر میکروبهای خاک و آب.
برای نوشتن پروپوزال میکروبشناسی محیطی، متدولوژیهای ارجح ما عبارتاند از:
- تحلیل و ارزیابی تغییرات میکروبی در پاسخ به آلودگیهای شیمیایی و فیزیکی
- بیورمیدیشن با میکروارگانیسمها
- مدلسازی و بررسی تأثیر تغییرات دما و رطوبت بر ساختار و عملکرد میکروارگانیسمها در خاک و منابع آبی
ویروسشناسی
ویروسشناسی از جذابترین شاخههای میکروبیولوژی است که با توجه به پاندمیها، هر روز توجه بیشتری را جلب میکند. ما با استفاده از جدیدترین روشها و فناوریها، کمک میکنیم تا در این حوزه، پروپوزالی قدرتمند و دقیق بنویسید. برخی از مهمترین متدولوژیها و تکنیکهای مورد استفاده ما در پروپوزالهای ویروسشناسی شامل موارد زیر است:
- مدلسازی اپیدمیولوژیک ویروسها و شبیهسازی گسترش ویروسها در جمعیتها با استفاده از مدلهای ریاضی
- توالییابی ژنوم ویروسی و بررسی جهشها و تغییرات ژنتیکی ویروسها با استفاده از فناوریهای توالییابی نسل جدید (NGS)
- استفاده از کشت سلولهای انسانی برای مطالعه اثرات ویروسها روی سلولها
- تستهای PCR اختصاصی ویروس و شناسایی دقیق و سریع ویروسها در نمونههای مختلف
- بررسی چگونگی تعامل ویروسها با سیستم ایمنی و سلولهای میزبان
قارچشناسی
پروپوزالهای این گرایش حول مباحثی چون شناسایی دقیق قارچهای بیماریزا، بررسی ویژگیهای بیولوژیکی آنها، و ارزیابی مقاومت دارویی در شرایط آزمایشگاهی و میدانی است. البته متدهای نوین برای شبیهسازی تعاملات قارچها با میزبان و مطالعه اثرات درمانی آنها در مدلهای مختلف ضروری هستند که ما آنها را به کار میبریم:
- استفاده از تکنیکهای توالییابی DNA برای شناسایی دقیق قارچهای بیماریزا
- آزمایشهای کشت و حساسیتسنجی برای تعیین مقاومت قارچها به داروهای مختلف
انگلشناسی پزشکی
داغترین مباحث پروپوزال انگلشناسی بهنوعی با شناسایی انگلهای مقاوم به دارو و مطالعه تعاملات پیچیده بین انگلها و سیستم ایمنی بدن مرتبط هستند. متخصصان پروپوزالچی، با استفاده از روشهای پیشرفته مانند توالییابی نسل جدید (NGS) و مدلهای حیوانی پیشرفته، این چالشها را بهطور دقیق و علمی برای شما حل خواهند کرد.
بهترین روشهایی که متخصصان ما در انجام پروپوزال میکروبیولوژی ارشد گرایش انگلشناسی پزشکی در نظر میگیرند:
- شناسایی انگلهای رودهای و خونی، استفاده از PCR و توالییابی ژنومی برای شناسایی دقیق انگلها در نمونههای بیولوژیکی
- مدلهای حیوانی انگلها و بررسی تعامل انگلها با سیستم ایمنی در مدلهای in vivo برای ارزیابی آسیبهای بافتی
- استفاده از آزمایشهای in vitro برای تعیین مقاومت انگلها به داروهای موجود و ارزیابی روشهای درمانی جدید
انجام پروپوزال دکتری میکروبیولوژی با رویکرد پژوهشی پیشرفته در پروپوزالچی
بیشک، برای نوشتن پروپوزال دکتری میکروبیولوژی، به تسلط کامل بر روشهای مولکولی پیشرفته، مدلسازیهای اپیدمیولوژیک پیچیده و دقت فوقالعاده در طراحی آزمایشها نیاز خواهد بود. چراکه تحقیقها و رسالههای دکتری، باید بر پایه تحلیل دادههای حجیم و تکنیکهای بیوانفورماتیک مانند تحلیل دادههای توالییابی نسل جدید (NGS) و پژوهشهای -omics صورت گیرند.
علاوه بر این، طراحی پروپوزال باید شامل شبیهسازیهای ریاضی و مدلسازیهای دقیق سیستمهای بیولوژیک برای پیشبینی واکنشهای پیچیده در میکروبها و میزبانها باشد. متخصصان ما در پروپوزالچی که از پژوهشگران برتر کشور هستند، با ارائه روششناسیهای بهروز و اختصاصی، کمک میکنند تا این چالش برطرف شود.
فرایند ویژهای را برای ارتباط مستقیم و آسان بین محقق پروپوزالچی و دانشجوی مقطع دکتری در نظر گرفتهایم. بدین ترتیب، هیچ دغدغهای از نظر جزئیات تکنیکی پیچیده نخواهید داشت.
در جدول زیر، رایجترین حوزههای تحقیقاتی دکتری میکروبیولوژی در ایران به همراه روششناسیهایی که ما معمولاً برای هر یک استفاده میکنیم، آورده شده است:
| حوزه تحقیقاتی | داغترین موضوعات | روشهای پیشنهادی پروپوزالچی |
|---|---|---|
| ویروسشناسی و اپیدمیولوژی ویروسها | شناسایی ویروسهای نوظهور، پاندمیهای جهانی و طراحی واکسنهای نوین | مدلسازی اپیدمیولوژیک با استفاده از مدلهای ریاضی و نرمافزاری، NGS برای تحلیل ژنوم ویروسی |
| میکروبهای بیماریزا و مقاومت دارویی | ایجاد مدلهای مقاوم به دارو در باکتریهای بیماریزا، مطالعه مقاومت باکتریها | PCR اختصاصی برای شناسایی جهشهای مقاومت، استفاده از متدولوژیهای ترابری ژنی مانند CRISPR |
| میکروبیوم روده و بیماریهای متابولیک | ارتباط میکروبیوم روده با دیابت، چاقی و اختلالات گوارشی | توالییابی میکروبیوم (16S rRNA Sequencing) و استفاده از بیوانفورماتیک برای تحلیل دادههای میکروبیولوژی |
| میکروبیولوژی محیطی و بیورمیدیشن | استفاده از میکروبها برای تجزیه آلایندههای شیمیایی و فلزات سنگین | آنالیز بیوفیلمها و مدلهای کشت میکروبی برای ارزیابی فعالیتهای بیورمیدیشن، شبیهسازیهای محیطی |
برای مشاهده جزئیات کامل خدمات ما در این مقطع، صفحه سفارش پروپوزال دکتری را مطالعه کنید.
مزایای انتخاب پروپوزالچی برای سفارش پروپوزال میکروبیولوژی
با تکیه بر تخصص و تجربه متخصصان خود، درک عمیقی از الزامات بخصوص رشته میکروبیولوژی به دست آوردهایم. صدها پروپوزال و تحقیق دانشجویی ارشد و دکتری میکروبشناسی را با جلب رضایت 95% دانشجویان با موفقیت تکمیل کردهایم. برخی از مزایای سفارش پروپوزال میکروبیولوژی در مؤسسه ما عبارتاند از:
- پشتیبانی از انجام پروپوزال انگلیسی و فارسی برای تطابق با الزامات داخلی و بینالمللی
- امکان سفارس پروپوزال فوری میکروبیولوژی با ضمانت کیفیت و آمادهشدن در زمان محدود
- پشتیبانی از تمامی گرایشهای رشته میکروبیولوژی
- مشاوره پروپوزال میکروبیولوژی 100% رایگان در برای انتخاب بهترین موضوع و ابزارهای آزمایشگاهی
- توسعه و تجزیه و تحلیل دادههای پیچیده با استفاده از تکنیکهای پیشرفته
- ارائه پیشنهادات کاربردی برای مطالعات آینده و روند تحقیقاتی نوین
- انجام ویرایش پروپوزال رایگان و نامحدود تا تأیید استاد
- پشتیبانی و پاسخگویی در هفت روز هفته

قیمت پروپوزال میکروبیولوژی ارشد و دکتری در پروپوزالچی
ما بر اساس نیازهای خاص هر پروژه، قیمتگذاری واقعبینانهای انجام میدهیم و نحوه قیمتگذاری را با ذکر جزئیات به سفارشدهنده گزارش خواهیم داد. بهطور کلی، قیمت نوشتن پروپوزال میکروبیولوژی در پروپوزالچی از 1.9 میلیون تومان شروع میشود و بسته به پیچیدگی پروژه، ممکن است افزایش یابد. با وجود مناسب بودن قیمت انجام پروپوزال میکروبیولوژی، کیفیت پروپوزالها را کاملاً تضمین میکنیم.
در جدول زیر، معیارهای اصلی تعیین قیمت پروپوزال رشته میکروبیولوژی در مؤسسه ما را میبینید:
| معیار | توضیحات |
|---|---|
| مقطع تحصیلی | هزینه انجام پروپوزال دکتری میکروبیولوژی معمولاً نسبت به انجام پروپوزال ارشد میکروبیولوژی، بالاتر است |
| پیچیدگی موضوع | اگر موضوع پروپوزال میکروبیولوژی پیچیده باشد یا به تجهیزات ویژه مانند NGS یا CRISPR نیاز داشته باشد، احتمال افزایش هزینه وجود دارد |
| زمان تحویل | انجام پروپوزال فوری و نیمهفوری (در بازه زمانی کوتاهتر از معمول) قیمت بیشتری خواهد داشت |
| نوع زبان پروپوزال | هزینه سفارش پروپوزال انگلیسی میتواند تا 2 برابر بیشتر از فارسی باشد |
چرا پروپوزال میکروبیولوژی چالشبرانگیز است؟ ما راهحل داریم!
نگارش پروپوزال میکروبیولوژی به دلیل آزمایشهای پیچیده و حساسیت تحلیل دادهها در این رشته، چالشی واقعی است. ازآنجایی که افتخار سالها خدمترسانی به شما عزیزان را در کارنامه خود داریم، به چالشهای مهم این حوزه آگاه هستیم. بهطور خاص، به 3 چالش ویژه در نگارش پروپوزال رشته میکروبیولوژی توجه بیشتری را معطوف میکنیم.

پیچیدگی طرحهای آزمایشگاه میکروبیولوژی و نیاز به تجهیزات پیشرفته
رشته میکروبیولوژی غالباً به بررسی آزمایشهای پیچیده و تجهیزات پیشرفته گره خورده است. درنتیجه، انتخاب روشهای تحقیق میکروبیولوژی که هم علمی و هم قابلاجرا باشند، برای دانشجویان این رشته دشوارتر میشود. برای مثال، دستگاههایی مانند PCR، میکروسکوپهای الکترونی و تجهیزات کشت سلولی به تخصص و دانش فنی ویژهای نیاز دارند که باید بهدرستی در متن لحاظ شوند.
این پیچیدگیها میتواند باعث سردرگمی دانشجویان شود؛ بهویژه در انتخاب دقیق متدولوژی و توجیه علمی آنها، که بخش مهمی از انجام پروپوزال میکروبیولوژی است. ما در پروپوزالچی با تجربه گستردهای که در این زمینه داریم، به شما کمک میکنیم تا طرح آزمایشگاهی دقیقی را بهطور حرفهای طراحی کرده و آن را با استفاده از بهروزترین تجهیزات و روشهای دنیا تنظیم کنید؛ بهگونهای متن شما هم از نظر علمی معتبر و هم از نظر اجرایی عملی باشد.
محدودیتهای موجود در انتخاب موضوعات نوآورانه و کاربردی
به شما در انتخاب موضوع پروپوزال کمک میکنیم تا موضوعات جذاب و نوآورانهای را انتخاب کنید که به چالشهای روز دنیای میکروبشناسی نیز پاسخ دهند. هماهنگی جدیدترین روشها و فناوریها با موضوعات را نیز حتماً در نظر میگیریم.
داغترین موضوعات میکروبیولوژی در سه سال اخیر به آنها پرداختهایم، عبارتاند از:
- ویرایش ژنوم با CRISPR-Cas9 برای ایجاد سویههای مقاوم یا حساس به داروهای خاص، بهویژه در باکتریها و مخمرها
- تحلیل ارتباط بین میکروبیوم روده و بیماریهایی مثل دیابت نوع 1 و روماتیسم مفصلی
- مقاومت آنتیبیوتیکی در محیطهای بیمارستانی
- مطالعه تکامل و پویایی ویروسهای جدید با استفاده از مدلهای ژنتیکی و اپیدمیولوژیک
- توسعه نانوذرات مبتنی بر مواد زیستی برای حمل دقیق داروهای ضدباکتری به بافتهای هدف، بهویژه در درمان عفونتهای مقاوم به دارو
حساسیت بالای پروپوزال برای اساتید میکروبیولوژی از نظر دقت و صحت دادهها
اساتید این حوزه، بیش از هرچیز به دقت دادهها و روششناسی تحقیقاتی حساس هستند. در این رشته، حتی کوچکترین خطا در جمعآوری یا تحلیل دادههای میکروبیولوژی میتواند اعتبار کل پروژه را زیر سوال ببرد. بهویژه در نوشتن پروپوزال میکروبیولوژی، استفاده از دادههای تجربی اشتباه یا نادقیق، مانند خطاهای تعیین غلظت محلولها یا آزمایش در شرایط کنترلشده اشتباه، از مهمترین علل رد شدن پروپوزال ارشد میکروبیولوژی است.
ما با رعایت دقیق استانداردهای علمی، ابزارهای آزمایشگاهی پیشرفته و روشهای آماری معتبر، تمام جوانب نگارش پروپوزال میکروبیولوژی را از ابتدا تا انتها بررسی میکنیم. این شامل طراحی دقیق آزمایشها با جزئیات بهروز، انتخاب متدولوژیهای معتبر و تحلیل دادهها به کمک نرمافزارهای پیشرفته آماری است. اینگونه با رعایت بالاترین استانداردهای علمی، مطمئن میشویم که پروپوزال برای اساتید شما 100% مورد تأیید باشد.
6 مرحله نوشتن پروپوزال میکروبیولوژی در مؤسسه پروپوزالچی
انجام پروپوزال میکروبیولوژی، زمانبر است و نیاز به رویکردی علمی و منظم دارد. مراحل نوشتن پروپوزال بهطور کلی در مؤسسه ما، چیزی شبیه به فرایند زیر است:
- انتخاب موضوع پروپوزال: انتخاب موضوعاتی که هم چالشبرانگیز باشند و هم در راستای نیازهای علمی و اجتماعی قرار گیرند.
- مرور پیشینه تحقیق: تحلیل و جمعآوری مقالات و منابع علمی معتبر برای نوشتن مبانی نظری پروپوزال.
- طراحی روششناسی دقیق: تعیین تکنیکها و ابزارهای آزمایشگاه میکروبیولوژی و مدلهای تحلیلی (مانند NGS یا CRISPR).
- شناسایی و تعریف متغیرهای تحقیقاتی: تعیین متغیرهای مستقل و وابسته بر اساس اهداف و فرضیات پژوهش.
- تدوین فرضیات علمی و سوالات تحقیقاتی: تعریف فرضیات علمی که شفاف و قابل آزمایش باشند.
- نوشتن بخشهای مختلف پروپوزال: نگارش بخشهای مختلف از جمله مقدمه، پیشینه، روششناسی، اهداف، ملاحظات اخلاقی، زمانبندی و انجام رفرنسدهی.
استانداردهای اخلاقی در میکروبشناسی: ما همهچیز را رعایت میکنیم
رعایت استانداردهای اخلاقی و ایمنی زیستی اهمیت ویژهای در این رشته دارد. جوانبی چون انتخاب روشهای تحقیقاتی و نحوه کار با مواد خطرناک، باید مطابق با قوانین و اصول بررسیهای علمی در میکروبیولوژی رعایت شوند. ما این استانداردها را بهطور کامل هنگام انجام پروپوزال میکروبیولوژی لحاظ میکنیم:
- رعایت ایمنی زیستی: تعیین سطح ایمنی مناسب (BSL-2 یا BSL-3) برای کار با پاتوژنها
- رعایت اصول Disposal: استفاده از روشهای صحیح برای دفع مواد بیولوژیکی خطرناک
- فرمهای کمیته اخلاق: تکمیل و رعایت فرمها و مجوزهای اخلاقی پیش از شروع تحقیق
- شفافیت در گزارشدهی: ارائه گزارشهای دقیق و شفاف از تمامی مراحل تحقیق
سوالات متداول
برای نوشتن پروپوزال میکروبشناسی، بهتر است از منابع معتبر و بهروز مانند مقالات علمی از ژورنالهای Elsevier، Springer و MDPI، کتب مرجع و مقالات پایاننامهها استفاده کنید.
کافیست از طریق تماس یا تکمیل فرم در وبسایت ما، درخواست خود را ثبت کنید. تیم ما پس از بررسی نیازهای شما، برای مشاوره پروپوزال میکروبیولوژی یا هماهنگی برای نهاییسازی سفارش، با شما ارتباط برقرار خواهد کرد.
پروپوزالهای رشته میکروبیولوژی شامل عنوان پژوهش، بیان مسئله، مبانی نظری، هدف تحقیق و فرضیات، روششناسی، ملاحظات اخلاقی، جدول زمانبندی و منابع هستند.
بسته به نوع تحقیق میکروبیولوژی، ممکن است پروپوزال شامل آزمایشهای کشت میکروبی یا تحلیلهای آزمایشگاهی برای شناسایی پاتوجنها باشد.
پروپوزال باید دقیق، نوآورانه و با روششناسی علمی و معتبر باشد. همچنین باید با شیوهنامه دانشگاهی و اصول اخلاقی همخوانی داشته باشد.
موضوع باید بر اساس علایق علمی، شکافهای موجود در تحقیقات و نیازهای علمی جامعه انتخاب شود. مطالعه مقالات جدید و مشاوره با اساتید میتواند کمک کند.
پروپوزالهای دکتری معمولاً نیاز به تحقیقات عمیقتر، نوآوریهای بیشتر و استفاده از تکنیکهای پیشرفتهتر مانند NGS و CRISPR دارند
سخن پایانی: چرا پروپوزالچی بهترین انتخاب شماست؟
اگر به دنبال پروپوزالی با دقت علمی بینظیر و نوآوریهای فراتر از معمول هستید، پروپوزالچی گزینهای است که نمیتوانید از دست بدهید. متخصصان میکروبیولوژی در مؤسسه ما با سابقه درخشان در انجام پروپوزال علمی تخصصی، شما را در هر قدم از مسیر تحقیقاتیتان همراهی میکنند. از تحلیل دادههای میکروبیولوژی تا انتخاب موضوعات نوآورانه، همه جزئیات را برای موفقیت شما به بهترین شکل ممکن پیادهسازی میکنیم. برای تجربهای متفاوت و حرفهای، همین حالا تماس بگیرید و انجام پروپوزال میکروبیولوژی خود را به ما بسپارید!
تیم ما از فارغالتحصیلان دانشگاههای شریف، تهران، شهید بهشتی و تربیت مدرس تشکیل شده است و از سال 1395 بهصورت تخصصی در زمینه نگارش پروپوزال برای دانشجویان ارشد و دکتری فعالیت داریم.
